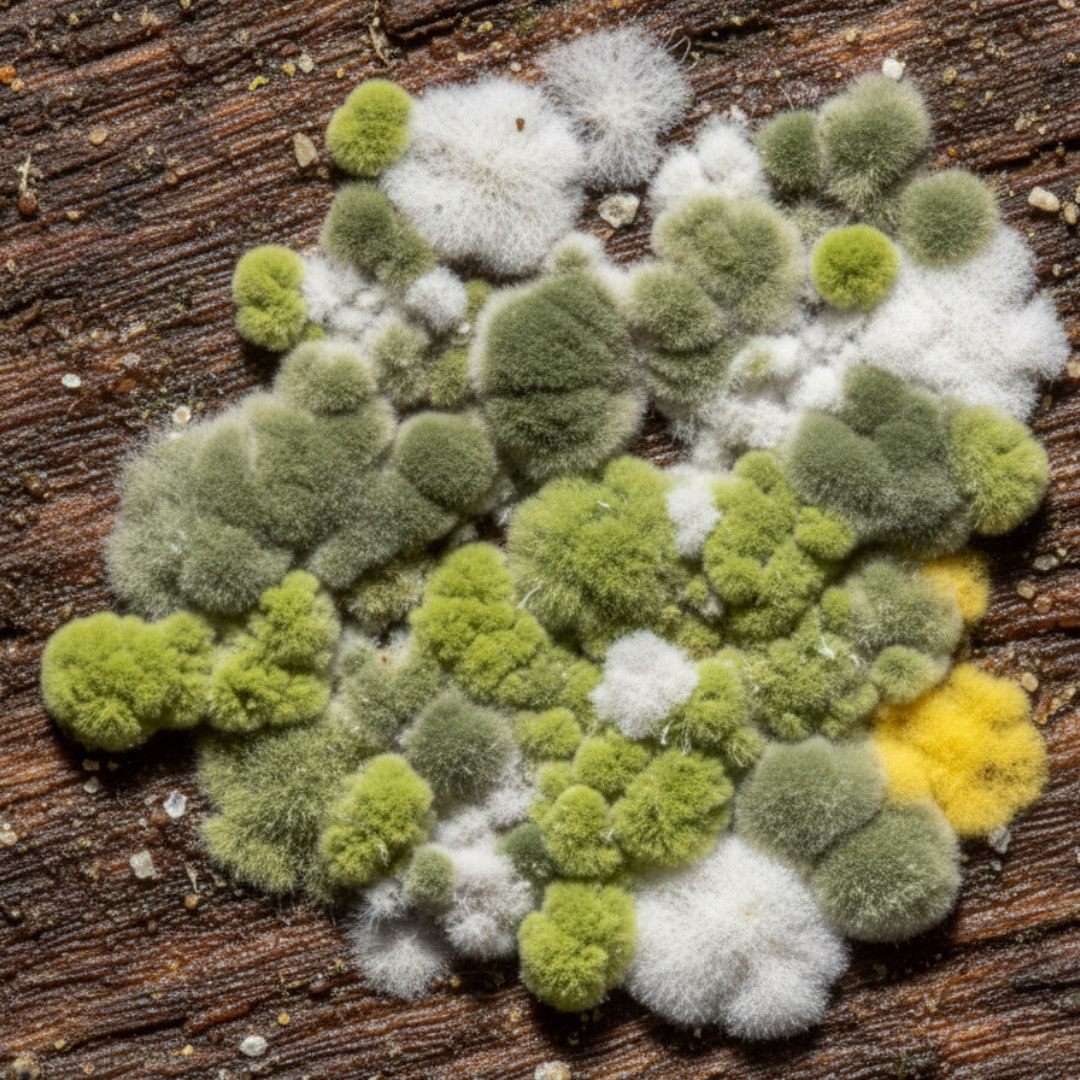

Our mission is to build a safer, healthier world through expert environmental analysis, trusted consulting, and effective restoration.
-

Careers
-

Locations
-

Contact us
Research and Environmental Science
Our teams are working to solve complex ecological challenges, advance environmental science, and build a more resilient future.
Charles Lehnhoff, CEO of Envirogyn and Sphaerus
"We approach our planet's environmental challenges with a sense of urgency and optimism. We believe in the power of science to not only identify problems but to deliver practical, restorative solutions."
Why We Do What We Do
From the beginning, our passion for applying science to solve real-world environmental and public health challenges has guided our work.
Meet Our People
Our strength is our team. We are a company of scientists, researchers, field experts, and advocates dedicated to making a tangible difference.
Our Community & Foundation
From the beginning, our passion for applying science to solve real-world environmental and public health challenges has guided our work.
-

The Envirogyn Foundation (Non-Profit)
Learn about our non-profit arm, which provides grants and pro-bono laboratory testing for underserved communities and local environmental groups.
-

Sustainability
Learn about our own work to achieve a net-zero footprint and operate as responsible stewards of the environment we're trying to protect.
-

Community Engagement
We’re building a more accessible understanding of science. See how we partner with schools and organizations to provide STEM education and environmental awareness.
We publish an annual Impact Report to transparently share our progress. We are proud to partner with leading universities, non-profits, and research institutions to amplify our work and drive meaningful, science-based change.
Our Impact & Key Partners
Get the latest news from Envirogyn in your inbox
Sign up to receive top stories from the week — from product announcements, to everyday tips.